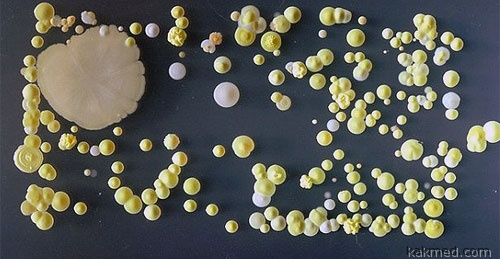
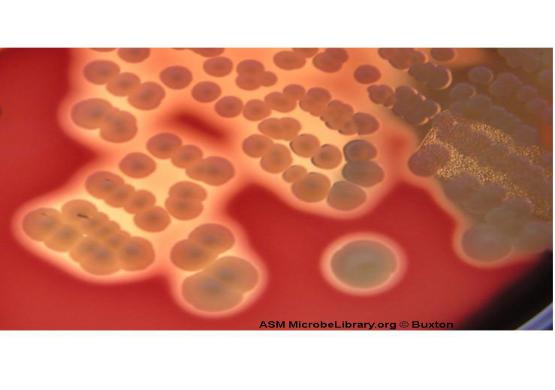

Лечение пазух носа и золотистого стафилококка в Калининграде
Лечение носа является одной из основных сфер работы лора. В клинике Потоцки в Польше есть все необходимое для борьбы с такими патологиями, как искривление перегородки, полипы и пр. Именно в лечении носа наиболее широко применяются хирургические методики.
Симптомы заболеваний носа чаще всего связаны с инфекционными или аллергическими причинами. Также это могут быть различные новообразования, а также скопления жидкости или слизи в носовых пазухах. Для точного выявления источников болезни следует пройти полное обследование у лора. Записаться на диагностику в нашей клинике можно в Калининграде по тел.: +7 (921) 262-29-59.
Заболевания носа и их лечение
Существует несколько видов распространенных патологий, лечение которых мы предлагаем:
- вазомоторный ринит;
- хронические синуситы;
- полипы носа;
- искривление перегородки;
- стафилококки.

Каждое из этих заболеваний вызывает проблемы с дыханием (хроническую заложенность носа), болевые ощущения, недомогание, потерю обоняния и множество других неприятных последствий вплоть до внешнего изменения формы носа. При этом медикаментозное лечение часто не дает существенного результата.
В клинике Потоцки в Польше установлены современные комплексы аппаратного и хирургического оборудования, позволяющие проводить малоинвазивные и эффективные процедуры для лечения пазух носа. Восстановление от таких операций не занимает много времени. Практически всегда пациенты покидают клинику в день операции и после соблюдения рекомендаций врача в течение нескольких дней возвращаются к нормальному жизненному распорядку.
Лечение стафилококка в носу
Помощь лора может понадобиться и при борьбе со стафилококком. Любопытно, что эти бактерии сопровождают человека всю его жизнь. Они проявляют себя только в периоды ослабления иммунитета, серьезных воспалительных процессах и травмах носа.
Особенно опасным является золотистый стафилококк. Обычно этой разновидности бактерии в организме нет. Она попадает в него извне и способна спровоцировать сильнейшие воспаления. Речь идет не только о ринитах, отитах или ангине. Поражаются все смежные органы дыхания и вызываются такие заболевания, как:
- бронхит;
- трахеит;
- аденоидит;
- гайморит.
При самых неблагоприятных сценариях, в случае отсутствия диагностики и лечения золотистого стафилококка, поражаются кости, сердце, почки, головной мозг. Особенно опасна бактерия для стариков и детей. Запомните симптомы, при которых нужно немедленно обратиться к лор-врачу: наличие примесей гноя в слизи из носа, нарушение обоняния, изменение тембра голоса, повышенная температура (до 39 градусов и более), общее недомогание, гайморит, фронтит.
Лечение стафилококка в носу у взрослых и детей должно быть своевременным и действенным. Чаще всего оно связано с приемом лекарственных средств, инъекциями препаратов и местной обработкой слизистой. При появлении гнойников может потребоваться и хирургическое вмешательство. Лечение золотистого стафилококка в носу у взрослых должно полностью контролироваться врачом. Это поможет избежать страшных последствий.
При появлении гнойников может потребоваться и хирургическое вмешательство. Лечение золотистого стафилококка в носу у взрослых должно полностью контролироваться врачом. Это поможет избежать страшных последствий.
Записаться на диагностику и лечение носа в клинике Потоцки в городе Бранево в 5 км от границы Польши и Калининградской области можно по телефону или через форму на сайте. Обратитесь к профессионалам и будьте здоровы!
Наука: Наука и техника: Lenta.ru
Нос человека содержит бактерии, которые производят эффективный антибиотик. Это выяснили немецкие бактериологи из Тюбингенского университета, которые хотели определить причины, по которым в носовой полости только двух третей всех людей живет и размножается золотистый стафилококк. Результаты исследования опубликованы в журнале Nature.
В большинстве случаев бактерии золотистого стафилококка (Staphylococcus aureus) являются безвредными, но иногда они вызывают сепсис, попадая, например, в открытую рану. S.aureus часто встречается в больницах, а один из его штаммов обладает лекарственной устойчивостью к антибиотикам пенициллинового ряда. Ежегодно от суперинфекций, вызванных стафилококком, погибает до 10 тысяч человек.
S.aureus часто встречается в больницах, а один из его штаммов обладает лекарственной устойчивостью к антибиотикам пенициллинового ряда. Ежегодно от суперинфекций, вызванных стафилококком, погибает до 10 тысяч человек.
Материалы по теме
00:09 — 22 июля 2016
Адские гончие
Как человека жестоко убивают обитающие в организме пузырьки
Ученые выяснили, что человеческий нос, в котором часто поселяется S.aureus, является агрессивной средой для микроба. В нем содержатся другие виды стафилококков, в частности, S. lugdunensis, который предотвращает рост потенциально патогенной бактерии. Это ему удается благодаря производству вещества, содержащего антибиотик. Исследователям удалось синтезировать соединение, названное лугдунином, в лаборатории. Эксперименты показали, что оно предотвращает рост колоний S.aureus в чашке Петри, а при нанесении на кожу мышей избавляет грызунов от инфекции.
Принцип работы лугдунина пока остается неясным. Бактериологи отмечают, что золотистый стафилококк не развивает устойчивость к нему, даже при воздействии низких доз антибиотика в течение 30 дней.
Исследователи изучили микробные популяции в носу госпитализированных пациентов и обнаружили, что 60 человек являются носителями S.aureus, а 17 — S. lugdunensis. При этом только у одного человека эти два вида микроорганизмов присутствовали одновременно, что указывает на то, что S. lugdunensis является врагом золотистого стафилококка.
Если длительное применение лугдунина действительно не вызывает появления супербактерий, которые устойчивы к лечению, то этот препарат может предотвратить закат эры антибиотиков, прогнозируемый многими специалистами. Ученые, однако, отмечают, что следует скептически относиться к такой возможности, и в будущем резистентность к новому антибактериальному соединению все-таки может проявиться.
В носу человека найден новый вид антибиотика
- Джеймс Галлахер
- Корреспондент по вопросам науки, BBC News
Анализируя бактерии, живущие внутри человеческого носа, ученые открыли новый вид антибиотиков.
Как сообщает журнала Nature, исследователи нашли соединение “лугдунин”, которое может бороться с инфекциями, порождаемыми супербактериями.
Последний раз новый класс антибиотиков был открыт в 1980-х годах.
Практически все антибиотики до этого были обнаружены в колониях почвенных бактерий, однако ученые из Тюбингенского университета в Германии впервые решили обратиться в своих исследованиях к человеческому телу. Они полагают, что наше тело – неисчерпаемый источник новых лекарств.
Страшные супербактерии
Наше тело не слишком похоже на поле боя, но на микроскопическом уровне внутри него постоянно идет борьба между конкурирующими видами бактерий.
И, как давно догадывались ученые, одно из оружий, которое применяется в этой борьбе, – это антибиотики.
Среди бактерий, которые любят брать штурмом человеческий нос, есть золотистый стафилококк. А также его супервид – метициллинрезистентный золотистый стафилококк (MRSA), устойчивый к большинству антибиотиков.
Он живет в носу 30% всех людей. Но как насчет остальных 70%?
Ученые обнаружили, что люди с конкурирующей бактерией Staphylococcus lugdunensis, живущей в их носах, с меньшей вероятностью будут атакованы опасным золотистым стафилококком.
Затем они использовали несколько штаммов генетически модифицированной Staphylococcus lugdunensis, чтобы выяснить, какая именно часть ее генетического кода оказалось решающей в борьбе за место в носу.
Именно так произошло важное открытие – один решающий ген содержал информацию, которую ученые использовали для создания нового антибиотика, получившего имя “лугдунин”.
Опыты на лабораторных мышах показали, что лугдунин способен лечить кожные инфекции, вызванные супербактериями, включая метициллинрезистентный золотистый стафилококк и фекальный энтерококк.
“Некоторые из подопытных животных были полностью излечены – на них не осталось ни одной клетки бактерии. В других случаях количество бактерий сократилось, часть из них осталась, но мы также увидели, что это соединение проникло вглубь ткани и действовало на более глубоких слоях кожи”, – рассказывает один из ученых, Бернхард Крисмер.
Прежде чем лугдунин будет предложен пациентам, должны пройти годы исследований, которые, кроме всего прочего, могут показать, что новый антибиотик не обладает заявленной эффективностью.
Но в любом случае, открытие новых антибиотиков необходимо. Медики по всему миру все чаще сталкиваются с тем, что инфекции вырабатывают устойчивость к имеющимся препаратам, а значит, рано или поздно могут стать неизлечимыми.
Богатое на открытия человеческое тело
Профессор Андреас Пешел считает, что человеческое тело должно быть исследовано на предмет новых видов антибиотиков.
“Лугдунин может стать первым примером таких антибиотиков – и мы уже запустили программу соответствующих исследований”, – говорит он.
Пешел полагает, что в будущем люди будут лечиться от инфекций путем искусственного заражения генетически-модифицированными бактериями.
“Путем введения лугдунина в безобидные виды бактерий мы надеемся разработать новый тип превентивных антибиотиков, которые смогут уничтожать болезнетворные организмы”, – поясняет профессор.
“Кажется удивительным, что часть человеческой микробиоты – всех бактерий, населяющих тело, – может быть источником антибиотиков, – замечают профессор Ким Льюис и доктор Филипп Штрандвиц из центра противомикробных исследований Северно-Восточного университета в США. – Тем не менее, микробиота состоит из более чем тысячи видов бактерий, многие из которых сражаются за питательные вещества и пространство внутри человеческого тела, и конкуренция с соседствующими бактериями очень высока”.
“Изменение баланса бактерий внутри тела путем производства натуральных антибиотиков может быть в итоге использовано для борьбы с бактериальными инфекциями, – считает профессор Колин Гарнер, глава британского Центра исследования антибиотиков. – Вполне возможно, что это исследование – первое в череде многих, доказывающих, что бактерии внутри нашего организма могут производить новые антибиотики с новыми химическими структурами”.
“Например, недавно был опубликован доклад о том, что у мужчин с бородой меньше болезнетворных микроорганизмов (включая метициллинрезистентный золотистый стафилококк), чем у мужчин, которые бреются. Это дает основания рассматривать открытие лугдунина в том же контексте, что и наличие растительности на лице – как защищающее нас от инфекций”, – добавляет профессор.
Это дает основания рассматривать открытие лугдунина в том же контексте, что и наличие растительности на лице – как защищающее нас от инфекций”, – добавляет профессор.
Симптомы и лечение золотистого стафилококка у взрослых и детей
Золотистый стафилококк – признаки и лечение. Симптомы золотистого стафилококка в кишечнике у взрослых
Золотистый стафилококк – аэробная бактерия, отличающаяся шарообразной формой и неподвижностью. Может провоцировать развитие разных заболеваний у детей. У взрослых встречается крайне редко. Анализ на золотистый стафилококк поможет выявить его присутствие в окружающей среде – на игрушках и посуде, постельном белье и коже человека, как абсолютно здорового, так и больного.
Классификация инфекции
В медицине выделяют две формы стафилококковой инфекции – генерализованную и очаговую. В первом случае речь идет о сепсисе, когда все системы и органы заражены стафилококком. Сепсис – опасное состояние, которое часто заканчивается летальным исходом даже на фоне оказания квалифицированной медицинской помощи.
Сепсис – опасное состояние, которое часто заканчивается летальным исходом даже на фоне оказания квалифицированной медицинской помощи.
Чаще диагностируется очаговая форма стафилококковой инфекции, когда выявляются заболевания кожных покровов, костной ткани, суставов. Отдельно врачи выделяют пищевое отравление токсинами – с характерными симптомами золотистого стафилококка в кишечнике у взрослых.
Стафилококковая инфекция может протекать в легкой, средней и тяжелой степени, острой или хронической форме.
Симптомы стафилококковой инфекции
Аэробную бактерию можно найти на поверхности кожи даже у здорового человека, поэтому удивляться ее наличию не стоит. Инфекция разовьется только в том случае, если «сработают» провоцирующие факторы – сниженный иммунитет, вирусное заболевание, хирургическое вмешательство, травмы, половая инфекция и так далее. Принято считать, что после лабораторного исследования посевов биоматериала, взятого из разных мест организма, можно выявить истинную угрозу наличия стафилококка.
Заболевания, вызванные рассматриваемой аэробной бактерией, не имеют каких-либо отличительных признаков. Если золотистый стафилококк поражает горло, то у человека может развиться ангина, фарингиты и ларингиты, отличающиеся тяжелым течением с высокой температурой тела и сильной слабостью. Заболевания дыхательной группы с частыми рецидивами считаются основным признаком присутствия бактерии в зеве.
Кроме этого, золотистый стафилококк может быть выявлен:
- в костной ткани – инфекция проникает при переломах или тяжелых ранениях;
- в фурункулах, карбункулах и абсцессах – как правило, инфицируется волосяная луковица, и процесс воспаления запускается снова и снова даже на фоне проводимого лечения;
- на коже – у ребенка появляются высыпания, дерматиты.

Нередко выявляется золотистый стафилококк у грудничка в кале. Диагностироваться это может еще в роддоме – инфицирование происходит во время тяжелых родов на фоне сниженного иммунитета у недоношенных детей или младенцев с врожденными патологиями.
Самое тяжелое состояние при инфицировании аэробной бактерией – токсический шок. Он отличается характерными симптомами – резким повышением температуры до критических показателей, тошнотой, острой болью в голове, сыпью на теле, появлением гнойного отделяемого из имеющихся ран. В таком случае никакие исследования не проводятся – только золотистый стафилококк может вызвать данное состояние. Назначается срочная терапия.
Лечение золотистого стафилококка
Антибиотики против золотистого стафилококка не всегда эффективны, поэтому их назначают лишь на начальной стадии развития заболевания. Эффективными будут только антибиотики последнего поколения – цефалоспорины и другие непенициллинового ряда.
Чаще всего врачи применяют комбинированную терапию. Если требуется лечение золотистого стафилококка в горле у ребенка, то будут назначены:
Если требуется лечение золотистого стафилококка в горле у ребенка, то будут назначены:
- обработка слизистой антисептическими растворами – хлорфиллиптом;
- иммуностимулирующие препараты;
- антистафилококковый бактериофаг.
Многих интересует, как вылечить золотистый стафилококк в зеве, который вызывает частые ангины, ларингиты, тонзиллиты. Без назначений врача не обойтись – привычные лекарственные препараты не помогают либо дают кратковременный эффект выздоровления. Специалист даст рекомендации по обработке слизистой глотки антисептическими растворами, проведет исследование на восприимчивость бактерии к антибиотикам и сделает медикаментозные назначения.
Чаще всего колонии рассматриваемых бактерий обнаруживаются в носу – они могут годами там находиться и не вызывать никаких заболеваний. Если же ребенок часто простужается, имеет отставание в росте и развитии, то хронических патологий не избежать. Как лечить золотистый стафилококк в носу у детей:
- госпитализировать ребенка в лечебное учреждение;
- проводить ежедневную санацию слизистой носа и глотки, так как имеется большой риск распространения инфекции;
- выполнять назначения врача для снятия тяжелых симптомов.

Независимо от того, какой именно орган поражен стафилококком, обязательно будут назначаться витамины, иммуномодуляторы и пробиотики для восстановления кишечной микрофлоры.
Длительность лечения стафилококковой инфекции – от 7 до 30 дней, что зависит от своевременности диагностирования заболевания и выявления больших колоний бактерии. Если терапия проводится в точном соблюдении назначений лечащего врача, то прогноз по заболеванию благоприятный.
Более подробно о том, как передается золотистый стафилококк и какие симптомы укажут на наличие аэробных бактерий, можно узнать на нашем сайте Добробут.ком.
Стафилококковая инфекция

МРЗС означает «метициллин-резистентный золотистый стафилококк» («Methicillin-Resistant Staph Aureus») В отличие от обычной стафилококковой инфекции, бактерии МРЗС устойчивы к воздействию обычных антибиотиков (antibiotics) и сложнее поддаются лечению. Кроме того, бактерии МРЗС более токсичны, чем обычные бактерии стафилококка. Они могут быстро распространяться в организме и вызывать опасное для жизни заболевание.
МРЗС передается при непосредственном физическом контакте с бактериями. МРЗС также передается через предметы, зараженные человеком, являющимся носителем бактерий, такие как повязки, полотенца, постельное белье или спортивный инвентарь. Обычно бактерии не передаются через воздух. Однако они могут передаваться при непосредственном контакте с жидкостью, выделяемой при кашле или чихании. Если у вас кожная инфекция МРЗС, существует риск рецидива в будущем.
При подозрении на инфекцию МРЗС врач может сделать посев выделений из раны (wound culture) для подтверждения диагноза. При наличии абсцесса он может быть дренирован. Вероятно, вам будет назначен один или несколько антибиотиков, которые действуют на МРЗС.
При наличии абсцесса он может быть дренирован. Вероятно, вам будет назначен один или несколько антибиотиков, которые действуют на МРЗС.
Уход в домашних условиях
Принимайте антибиотики в точном соответствии с назначением. Даже если вы почувствовали себя лучше, не прекращайте принимать их, пока они не закончатся, или до тех пор, пока не получите указание прекратить их прием от своего лечащего врача.
Если вам была назначена мазь с антибиотиком, применяйте ее в соответствии с полученными указаниями.
В течение 5 дней ежедневно мойте все тело (от волосистой части головы до пальцев ног) специальным мылом. Два раза в день чистите ногти пальцев рук в течение 1 минуты щеткой со специальным мылом.
Раны должны быть закрыты чистыми и сухими повязками. Если повязки загрязнились, их необходимо заменить. Каждый раз, когда вы меняете повязку или касаетесь раны, тщательно мойте руки.
Если у вас наращенные ногти или лак на ногтях, их необходимо снять.

Лечение членов семьи
Если у вас диагностировано возможное заражение инфекцией МЗРМ, ваши близкие, живущие вместе с вами, подвержены более высокому риску наличия бактерий на коже или в носу, даже при отсутствии признаков инфекции. Бактерии необходимо удалить с кожи всех членов семьи одновременно, чтобы они не передавались от одного к другому. Проинструктируйте их, как следует удалить бактерии:
Члены семьи должны использовать специальное мыло, как описано выше.
Если у кого-либо из членов семьи имеется кожная инфекция, ее должен лечить врач. Чтобы вылечить инфекцию МРЗС, мытья не достаточно.
Очистите столешницы и детские игрушки.
Каждый член семьи должен пользоваться только своими предметами личного обихода, такими как зубные щетки или бритвенные станки. При этом пользоваться общими очками, тарелками и столовыми приборами разрешается.
Предотвращение распространения инфекции.
Часто мойте руки простым мылом и теплой водой.
 Обязательно очищайте зоны под ногтями, между пальцами и запястья. Вытирайте руки одноразовыми полотенцами (например, бумажными). Если нет возможности воспользоваться мылом и водой, можно использовать антисептик для рук на основе спирта. Втирайте антисептик по всей поверхности рук, пальцев и запястий до полного высыхания.
Обязательно очищайте зоны под ногтями, между пальцами и запястья. Вытирайте руки одноразовыми полотенцами (например, бумажными). Если нет возможности воспользоваться мылом и водой, можно использовать антисептик для рук на основе спирта. Втирайте антисептик по всей поверхности рук, пальцев и запястий до полного высыхания.Не пользуйтесь чужими предметами личного обихода, такими как полотенца, бритвенные станки, одежда или униформа. Стирайте постельное белье, полотенца и одежду в горячей воде со стиральным порошком. Устанавливайте для сушилки режим высокой температуры, чтобы убить оставшиеся бактерии.
Если вы посещаете тренажерный зал, до и после каждого применения протирайте инвентарь антисептиком на основе спирта. Также протирайте все ручки и места, за которые беретесь руками.
Если вы занимаетесь спортом, после каждой тренировки принимайте душ с обычным мылом. Каждый раз после душа используйте чистое полотенце.
Последующее наблюдение
Приходите на контрольные приемы, назначенные вашим врачом, или в соответствии с указаниями, полученными от наших сотрудников. Если был сделан посев выделений из раны, получите результаты в указанное время. Если в ваш курс лечения будут внесены какие-либо изменения, вам о них сообщат.
Если был сделан посев выделений из раны, получите результаты в указанное время. Если в ваш курс лечения будут внесены какие-либо изменения, вам о них сообщат.
Если у вас был диагностирован МРЗС, в будущем вам необходимо будет сообщать медицинскому персоналу о том, что вы проходили лечение от этой инфекции.
Когда необходимо обратиться за медицинской помощью
В любом из следующих случаев обратитесь в обслуживающее вас медицинское учреждение:
Усиливающееся покраснение, опухание или боль
Красные полосы в коже вокруг раны
Слабость или головокружение
Появление гноя или выделений из раны
Температура выше 100,4 ºF (38,0 ºС) или в соответствии с указаниями вашего лечащего врача
О стафилококке и стафилококковой инфекции — Министерство здравоохранения ПМР
Стафилококки – это целый род микроорганизмов, на сегодня известно уже 27 видов, при этом 14 видов обнаружены на коже и слизистых оболочках человека.
Практически все связанные со стафилококком медицинские проблемы подразумевают присутствие именно золотистого стафилококка, обладающего удивительной живучестью: не теряет активности при высушивании, 12 часов живет под воздействием прямых солнечных лучей, в течение 30 минут выдерживает температуру в 800 С, не погибает в чистом этиловом спирте, не боится перекиси водорода.
Стафилококки распространены повсеместно, их можно обнаружить практически на любом участке человеческого тела и окружающих предметах. В течение первой недели жизни у 90% новорожденных в полости носа выявляется золотистый стафилококк. В первые два года жизни у 20% детей обнаруживаются золотистые стафилококки в полости носа, а к 4-6 годам они обнаруживаются у 30-50%, у взрослых носительство колеблется в пределах 12-50%.
В первые два года жизни у 20% детей обнаруживаются золотистые стафилококки в полости носа, а к 4-6 годам они обнаруживаются у 30-50%, у взрослых носительство колеблется в пределах 12-50%.
Важно всегда разграничивать такие понятия, как стафилококк и стафилококковая инфекция. Золотистый стафилококк является условно-патогенным микроорганизмом, представителем нормальной человеческой микрофлоры. Термин «условно-патогенный» означает, что стафилококк вызывает заболевание лишь при определенных обстоятельствах. Он может находиться в организме долгое время (хоть всю жизнь), не причиняя человеку вреда и должны создаться определенные условия, чтобы он вызвал болезнь. А именно – ослабление иммунитета. Если иммунная защита человека работает нормально, стафилококк существует в организме, не причиняя «хозяину» никакого беспокойства. Если иммунитет дает сбой, стафилококк может атаковать организм человека, что ведет к появлению самых различных болезней (более ста наименований): от относительно легких кожных гнойничковых инфекций до таких тяжелых процессов как пневмония (воспаление легких), менингит (воспаление оболочек мозга), остеомиелит (поражение костей), сепсис (воспалительный процесс во всех органах человека или «заражение крови»), токсический шок и другие. Самая распространенная токсическая стафилококковая болезнь – пищевая токсикоинфекция.
Самая распространенная токсическая стафилококковая болезнь – пищевая токсикоинфекция.
Безусловно, стафилококковые инфекции подлежат лечению. Этим занимаются врачи различных специальностей. Лечение стафилококковых болезней – удивительно сложная задача, ибо нет микроба, способного сравниться со стафилококком по способности вырабатывать устойчивость к антибиотикам и другим антибактериальным средствам. Поэтому лечение необходимо назначать только после определения чувствительности к антибактериальным средствам. С этим согласны все специалисты.
Сложнее обстоят дела при здоровом носительстве, когда микроб присутствует в организме человека (например, на слизистой носоглотки), но заболевание не развивается вследствие равновесия факторов агрессии микроба и защитных сил иммунной системы человека. Вместе с тем, носитель может представлять серьезную опасность для окружающих. Особенно опасен такой человек, если он работает в пищевой отрасли (повар, раздатчик готовых блюд), в медицине (медицинская сестра детского отделения, врач хирург или акушер-гинеколог и др. ).
).
Вопросы лечения носительства золотистого стафилококка будоражат медицинскую общественность не одно десятилетие. Когда с этой условно-патогенной бактерией нужно бороться, а когда — нет? Что делать с устойчивым штаммом? Чем его лечить?
Носительство без симптомов лечить не нужно! Ничем и никогда. Живите спокойно и забудьте об этом анализе. Если у совершенно здорового ребенка или взрослого вдруг в посеве кала (грудного молока, мазка из носоглотки, зева, влагалища и так далее) высевается золотистый стафилококк, лечить его не имеет никакого смысла.
При носительстве с симптомами нужно быть полностью уверенным, что они имеют отношение к золотистому стафилококку. Только в таком случае, после консультации врача, можно брать рецепт и идти в аптеку.
Обязательному лечению подлежат люди, которые, будучи носителями стафилококка, при исполнении своих профессиональных обязанностей могут вызвать возникновение стафилококковой инфекции у других людей. Список профессий, представители которых подлежат лечению в связи с носительством стафилококка, оговорен специальным директивным документом. Помимо медицинских работников в него входят, например, работники сферы общественного питания. Опасность стафилококконосительства в этой категории состоит еще и в том, что стафилококки могут попасть в приготавливаемую пищу и вызвать массовое заболевание пищевой токсикоинфекцией. Также имеет смысл проходить лечение здоровым носителям стафилококка, проживающим совместно с людьми, которые страдают повторными стафилококковыми инфекциями (например, фурункулезом) или тяжелыми хроническими болезнями.
Помимо медицинских работников в него входят, например, работники сферы общественного питания. Опасность стафилококконосительства в этой категории состоит еще и в том, что стафилококки могут попасть в приготавливаемую пищу и вызвать массовое заболевание пищевой токсикоинфекцией. Также имеет смысл проходить лечение здоровым носителям стафилококка, проживающим совместно с людьми, которые страдают повторными стафилококковыми инфекциями (например, фурункулезом) или тяжелыми хроническими болезнями.
Лечение носительства золотистого стафилококка антибиотиками нецелесообразно. В арсенале специалистов достаточно других средств. Лечение антибиотиками дисбактериоза с высоким содержанием стафилококка вовсе противопоказано, так как это приведет к противоположному результату – более интенсивному размножению стафилококка.
Профилактика стафилококковой инфекции включает в себя: соблюдение правил личной гигиены, отказ от вредных привычек, здоровое питание и полноценный сон. Необходимо избегать общих переохлаждений и перегревов, своевременно обрабатывать антисептиками (йод, зеленка) микротравмы кожи. Необходимо выявлять и лечить носителей золотистого стафилококка, особенно работающих в учреждениях здравоохранения и общественного питания, на время лечения такие лица не допускаются к исполнению своих обязанностей
Необходимо выявлять и лечить носителей золотистого стафилококка, особенно работающих в учреждениях здравоохранения и общественного питания, на время лечения такие лица не допускаются к исполнению своих обязанностей
Ни в коем случае не отчаивайтесь, если у Вас обнаружен стафилококк. Победить его можно, сделать это будет легче при своевременном обращении к врачу и четком выполнении рекомендаций по лечению и профилактике, впрочем, это правило относится к любому заболеванию. Всегда согласовывайте свои действия с врачом.
Будьте здоровы.
Врач эпидемиолог С. С. Пынзарь
Бактериологическое исследование слизи из носа на стафилококк (Staphilococcus aureus)
АНМО «Ставропольский краевой клинический консультативно-диагностический центр»:
355017, г. Ставрополь, ул. Ленина 304(8652) 951-951, (8652) 35-61-49 (факс)
(8652) 951-951, (8652) 31-51-51 (справочная служба)
Посмотреть подробнееОбособленное подразделение «Диагностический центр на Западном обходе»:
355029 г. Ставрополь, ул. Западный обход, 64
Ставрополь, ул. Западный обход, 64 (8652) 951-951, (8652) 31-51-51 (контактный телефон)
(8652) 31-68-89 (факс)
Посмотреть подробнееКлиника семейного врача:
355017 г. Ставрополь, пр. К. Маркса, 110 (за ЦУМом)(8652) 951-951, (8652) 31-51-51 (контактный телефон)
(8652) 31-50-60 (регистратура)
Посмотреть подробнееНевинномысский филиал:
357107, г. Невинномысск, ул. Низяева 1(86554) 95-777, 8-962-400-57-10 (регистратура)
Посмотреть подробнееОбособленное структурное подразделение в г. Черкесске :
369000, г. Черкесск, ул. Умара Алиева 318(8782) 26-48-02, +7-988-700-81-06 (контактные телефоны)
Посмотреть подробнееОбособленное структурное подразделение в г. Элисте :
Элисте :
8(989) 735-42-07 (контактные телефоны)
Посмотреть подробнееЗАО “Краевой клинический диагностический центр”:
355017 г. Ставрополь, ул. Ленина 304(8652) 951-951, (8652) 35-61-49 (факс)
(8652) 951-951, (8652) 31-51-51 (справочная служба)
Посмотреть подробнееОбособленное структурное подразделение на ул. Савченко, 38 корп. 9:
355021, г. Ставрополь, ул. Савченко, 38, корп. 98 (8652) 316-847 (контактный телефон)
Посмотреть подробнееОбособленное структурное подразделение на ул. Чехова, 77 :
355000, г. Ставрополь, ул. Чехова, 778(8652) 951-943 (контактный телефон)
Посмотреть подробнееОбособленное структурное подразделение в г. Михайловске:
Михайловске:
8(988) 099-15-55 (контактный телефон)
Посмотреть подробнееСимптомы, причины, диагностика и лечение
Стафилококковая инфекция – это бактериальная инфекция, вызываемая бактериями Staphylococcus , которые довольно часто встречаются в окружающей среде.
Инфекция, вызванная бактериями стафилококка, может вызвать различные кожные заболевания, в том числе:
Эти кожные заболевания не заразны, но бактерии, их вызывающие, заразны. Бактерии распространяются либо при личном контакте, либо при прикосновении к зараженному предмету, например дверной ручке.
Бактерии стафилококка обычно скапливаются в носовых проходах, поэтому нос является частым местом заражения стафилококком.
Общие типы инфекций носового стафилококка включают:
- Носовой вестибулит.
 Это инфекция передней части носовой полости. Это может вызвать корки и кровотечение.
Это инфекция передней части носовой полости. Это может вызвать корки и кровотечение. - Фолликулит. Это инфекция одного или нескольких волосяных фолликулов.
- Кипит. Фурункул, также называемый фурункулом, представляет собой более глубокую инфекцию вокруг волосяного фолликула или сальной железы, через которую может стекать гной, если он прорывается.
Читайте дальше, чтобы узнать больше о стафилококковых инфекциях в носу, включая общие симптомы и способы их лечения.
Возможные симптомы стафилококковой инфекции носа включают:
- отек
- покраснение
- корки
- легкое кровотечение
- очаги, из которых сочится гной или жидкость
- боль или болезненность
- лихорадка
контакт с бактериями стафилококка на ежедневной основе, но не всегда вызывает инфекцию.Однако если у вас есть трещина на коже, например порез, царапина или ожог, бактерии могут попасть в ваше тело и вызвать инфекцию.![]()
Есть несколько факторов, которые могут вызвать разрыв нежной кожи внутри носа, в том числе:
- чрезмерное сморкание
- ковыряние в носу
- выщипывание или выщипывание волос в носу
- пирсинг в носу
Кому подтвердите, что у вас инфекция носового стафилококка, лучше проконсультироваться с вашим лечащим врачом.Они осмотрят ваш нос и спросят о ваших симптомах. Они могут взять образец ткани или выделений из носа для анализа в лаборатории на наличие бактерий.
Тестирование может помочь определить, вызвана ли инфекция метициллин-резистентным Staphylococcus aureus (MRSA). MRSA – это тип стафилококковых бактерий, устойчивых ко многим типам антибиотиков, поэтому он требует осторожного лечения.
Антибиотики лечат стафилококковые инфекции. Ваш врач может прописать вам пероральные антибиотики, мазь с антибиотиком для местного применения или и то, и другое.
Если у вас MRSA, ваш врач, вероятно, пропишет вам более сильный антибиотик или даже внутривенные антибиотики, если инфекция тяжелая или не поддается лечению.
важно!Убедитесь, что вы прошли полный курс антибиотиков в соответствии с предписаниями врача, даже если вы почувствуете себя лучше до их окончания. В противном случае вы не сможете убить все бактерии, что сделает их устойчивыми к антибиотикам.
Если у вас большой фурункул или другое поражение, вам может потребоваться его дренирование.Не поддавайтесь желанию выпить или осушить его самостоятельно. Это может вызвать распространение инфекции.
Легкие стафилококковые инфекции часто проходят самостоятельно без какого-либо лечения.
Однако некоторые стафилококковые инфекции могут быстро стать серьезными и вызвать определенные осложнения, например:
- Целлюлит. Инфекция возникает в более глубоких слоях кожи.
- Тромбоз кавернозного синуса. Это редкое, но серьезное осложнение носовых или лицевых инфекций связано с образованием сгустка крови в основании вашего мозга.

- Сепсис. Это состояние, потенциально опасное для жизни, является крайней реакцией вашего организма на инфекцию.
Бактерии стафилококка обычно присутствуют в полости носа и на коже. Обычно эти бактерии безвредны. Но они могут вызвать инфекцию, если попадут в ваше тело через разрыв кожи.
Если вы заметили в носу покраснение или раздражение, не спускайте с него глаз. Если он становится болезненным, образует шишку или поражение, заполненное гноем или жидкостью, обратитесь за медицинской помощью, чтобы избежать более серьезной инфекции.
Симптомы, причины, диагностика и лечение
Стафилококковая инфекция – это бактериальная инфекция, вызываемая бактериями Staphylococcus , которые довольно часто встречаются в окружающей среде.
Инфекция, вызванная бактериями стафилококка, может вызвать различные кожные заболевания, в том числе:
Эти кожные заболевания не заразны, но бактерии, их вызывающие, заразны. Бактерии распространяются либо при личном контакте, либо при прикосновении к зараженному предмету, например дверной ручке.
Бактерии стафилококка обычно скапливаются в носовых проходах, поэтому нос является частым местом заражения стафилококком.
Общие типы инфекций носового стафилококка включают:
- Носовой вестибулит. Это инфекция передней части носовой полости. Это может вызвать корки и кровотечение.
- Фолликулит. Это инфекция одного или нескольких волосяных фолликулов.
- Кипит. Фурункул, также называемый фурункулом, представляет собой более глубокую инфекцию вокруг волосяного фолликула или сальной железы, через которую может стекать гной, если он прорывается.
Читайте дальше, чтобы узнать больше о стафилококковых инфекциях в носу, включая общие симптомы и способы их лечения.
Возможные симптомы стафилококковой инфекции носа включают:
- отек
- покраснение
- корки
- легкое кровотечение
- очаги, из которых сочится гной или жидкость
- боль или болезненность
- лихорадка
контакт с бактериями стафилококка на ежедневной основе, но не всегда вызывает инфекцию. Однако если у вас есть трещина на коже, например порез, царапина или ожог, бактерии могут попасть в ваше тело и вызвать инфекцию.
Однако если у вас есть трещина на коже, например порез, царапина или ожог, бактерии могут попасть в ваше тело и вызвать инфекцию.
Есть несколько факторов, которые могут вызвать разрыв нежной кожи внутри носа, в том числе:
- чрезмерное сморкание
- ковыряние в носу
- выщипывание или выщипывание волос в носу
- пирсинг в носу
Кому подтвердите, что у вас инфекция носового стафилококка, лучше проконсультироваться с вашим лечащим врачом.Они осмотрят ваш нос и спросят о ваших симптомах. Они могут взять образец ткани или выделений из носа для анализа в лаборатории на наличие бактерий.
Тестирование может помочь определить, вызвана ли инфекция метициллин-резистентным Staphylococcus aureus (MRSA). MRSA – это тип стафилококковых бактерий, устойчивых ко многим типам антибиотиков, поэтому он требует осторожного лечения.
Антибиотики лечат стафилококковые инфекции. Ваш врач может прописать вам пероральные антибиотики, мазь с антибиотиком для местного применения или и то, и другое.
Если у вас MRSA, ваш врач, вероятно, пропишет вам более сильный антибиотик или даже внутривенные антибиотики, если инфекция тяжелая или не поддается лечению.
важно!Убедитесь, что вы прошли полный курс антибиотиков в соответствии с предписаниями врача, даже если вы почувствуете себя лучше до их окончания. В противном случае вы не сможете убить все бактерии, что сделает их устойчивыми к антибиотикам.
Если у вас большой фурункул или другое поражение, вам может потребоваться его дренирование.Не поддавайтесь желанию выпить или осушить его самостоятельно. Это может вызвать распространение инфекции.
Легкие стафилококковые инфекции часто проходят самостоятельно без какого-либо лечения.
Однако некоторые стафилококковые инфекции могут быстро стать серьезными и вызвать определенные осложнения, например:
- Целлюлит. Инфекция возникает в более глубоких слоях кожи.
- Тромбоз кавернозного синуса.
 Это редкое, но серьезное осложнение носовых или лицевых инфекций связано с образованием сгустка крови в основании вашего мозга.
Это редкое, но серьезное осложнение носовых или лицевых инфекций связано с образованием сгустка крови в основании вашего мозга. - Сепсис. Это состояние, потенциально опасное для жизни, является крайней реакцией вашего организма на инфекцию.
Бактерии стафилококка обычно присутствуют в полости носа и на коже. Обычно эти бактерии безвредны. Но они могут вызвать инфекцию, если попадут в ваше тело через разрыв кожи.
Если вы заметили в носу покраснение или раздражение, не спускайте с него глаз. Если он становится болезненным, образует шишку или поражение, заполненное гноем или жидкостью, обратитесь за медицинской помощью, чтобы избежать более серьезной инфекции.
Симптомы, причины, диагностика и лечение
Стафилококковая инфекция – это бактериальная инфекция, вызываемая бактериями Staphylococcus , которые довольно часто встречаются в окружающей среде.
Инфекция, вызванная бактериями стафилококка, может вызвать различные кожные заболевания, в том числе:
Эти кожные заболевания не заразны, но бактерии, их вызывающие, заразны. Бактерии распространяются либо при личном контакте, либо при прикосновении к зараженному предмету, например дверной ручке.
Бактерии распространяются либо при личном контакте, либо при прикосновении к зараженному предмету, например дверной ручке.
Бактерии стафилококка обычно скапливаются в носовых проходах, поэтому нос является частым местом заражения стафилококком.
Общие типы инфекций носового стафилококка включают:
- Носовой вестибулит. Это инфекция передней части носовой полости. Это может вызвать корки и кровотечение.
- Фолликулит. Это инфекция одного или нескольких волосяных фолликулов.
- Кипит. Фурункул, также называемый фурункулом, представляет собой более глубокую инфекцию вокруг волосяного фолликула или сальной железы, через которую может стекать гной, если он прорывается.
Читайте дальше, чтобы узнать больше о стафилококковых инфекциях в носу, включая общие симптомы и способы их лечения.
Возможные симптомы стафилококковой инфекции носа включают:
- отек
- покраснение
- корки
- легкое кровотечение
- очаги, из которых сочится гной или жидкость
- боль или болезненность
- лихорадка
контакт с бактериями стафилококка на ежедневной основе, но не всегда вызывает инфекцию. Однако если у вас есть трещина на коже, например порез, царапина или ожог, бактерии могут попасть в ваше тело и вызвать инфекцию.
Однако если у вас есть трещина на коже, например порез, царапина или ожог, бактерии могут попасть в ваше тело и вызвать инфекцию.
Есть несколько факторов, которые могут вызвать разрыв нежной кожи внутри носа, в том числе:
- чрезмерное сморкание
- ковыряние в носу
- выщипывание или выщипывание волос в носу
- пирсинг в носу
Кому подтвердите, что у вас инфекция носового стафилококка, лучше проконсультироваться с вашим лечащим врачом.Они осмотрят ваш нос и спросят о ваших симптомах. Они могут взять образец ткани или выделений из носа для анализа в лаборатории на наличие бактерий.
Тестирование может помочь определить, вызвана ли инфекция метициллин-резистентным Staphylococcus aureus (MRSA). MRSA – это тип стафилококковых бактерий, устойчивых ко многим типам антибиотиков, поэтому он требует осторожного лечения.
Антибиотики лечат стафилококковые инфекции. Ваш врач может прописать вам пероральные антибиотики, мазь с антибиотиком для местного применения или и то, и другое.
Если у вас MRSA, ваш врач, вероятно, пропишет вам более сильный антибиотик или даже внутривенные антибиотики, если инфекция тяжелая или не поддается лечению.
важно!Убедитесь, что вы прошли полный курс антибиотиков в соответствии с предписаниями врача, даже если вы почувствуете себя лучше до их окончания. В противном случае вы не сможете убить все бактерии, что сделает их устойчивыми к антибиотикам.
Если у вас большой фурункул или другое поражение, вам может потребоваться его дренирование.Не поддавайтесь желанию выпить или осушить его самостоятельно. Это может вызвать распространение инфекции.
Легкие стафилококковые инфекции часто проходят самостоятельно без какого-либо лечения.
Однако некоторые стафилококковые инфекции могут быстро стать серьезными и вызвать определенные осложнения, например:
- Целлюлит. Инфекция возникает в более глубоких слоях кожи.
- Тромбоз кавернозного синуса.
 Это редкое, но серьезное осложнение носовых или лицевых инфекций связано с образованием сгустка крови в основании вашего мозга.
Это редкое, но серьезное осложнение носовых или лицевых инфекций связано с образованием сгустка крови в основании вашего мозга. - Сепсис. Это состояние, потенциально опасное для жизни, является крайней реакцией вашего организма на инфекцию.
Бактерии стафилококка обычно присутствуют в полости носа и на коже. Обычно эти бактерии безвредны. Но они могут вызвать инфекцию, если попадут в ваше тело через разрыв кожи.
Если вы заметили в носу покраснение или раздражение, не спускайте с него глаз. Если он становится болезненным, образует шишку или поражение, заполненное гноем или жидкостью, обратитесь за медицинской помощью, чтобы избежать более серьезной инфекции.
Симптомы, причины, диагностика и лечение
Стафилококковая инфекция – это бактериальная инфекция, вызываемая бактериями Staphylococcus , которые довольно часто встречаются в окружающей среде.
Инфекция, вызванная бактериями стафилококка, может вызвать различные кожные заболевания, в том числе:
Эти кожные заболевания не заразны, но бактерии, их вызывающие, заразны. Бактерии распространяются либо при личном контакте, либо при прикосновении к зараженному предмету, например дверной ручке.
Бактерии распространяются либо при личном контакте, либо при прикосновении к зараженному предмету, например дверной ручке.
Бактерии стафилококка обычно скапливаются в носовых проходах, поэтому нос является частым местом заражения стафилококком.
Общие типы инфекций носового стафилококка включают:
- Носовой вестибулит. Это инфекция передней части носовой полости. Это может вызвать корки и кровотечение.
- Фолликулит. Это инфекция одного или нескольких волосяных фолликулов.
- Кипит. Фурункул, также называемый фурункулом, представляет собой более глубокую инфекцию вокруг волосяного фолликула или сальной железы, через которую может стекать гной, если он прорывается.
Читайте дальше, чтобы узнать больше о стафилококковых инфекциях в носу, включая общие симптомы и способы их лечения.
Возможные симптомы стафилококковой инфекции носа включают:
- отек
- покраснение
- корки
- легкое кровотечение
- очаги, из которых сочится гной или жидкость
- боль или болезненность
- лихорадка
контакт с бактериями стафилококка на ежедневной основе, но не всегда вызывает инфекцию. Однако если у вас есть трещина на коже, например порез, царапина или ожог, бактерии могут попасть в ваше тело и вызвать инфекцию.
Однако если у вас есть трещина на коже, например порез, царапина или ожог, бактерии могут попасть в ваше тело и вызвать инфекцию.
Есть несколько факторов, которые могут вызвать разрыв нежной кожи внутри носа, в том числе:
- чрезмерное сморкание
- ковыряние в носу
- выщипывание или выщипывание волос в носу
- пирсинг в носу
Кому подтвердите, что у вас инфекция носового стафилококка, лучше проконсультироваться с вашим лечащим врачом.Они осмотрят ваш нос и спросят о ваших симптомах. Они могут взять образец ткани или выделений из носа для анализа в лаборатории на наличие бактерий.
Тестирование может помочь определить, вызвана ли инфекция метициллин-резистентным Staphylococcus aureus (MRSA). MRSA – это тип стафилококковых бактерий, устойчивых ко многим типам антибиотиков, поэтому он требует осторожного лечения.
Антибиотики лечат стафилококковые инфекции. Ваш врач может прописать вам пероральные антибиотики, мазь с антибиотиком для местного применения или и то, и другое.
Если у вас MRSA, ваш врач, вероятно, пропишет вам более сильный антибиотик или даже внутривенные антибиотики, если инфекция тяжелая или не поддается лечению.
важно!Убедитесь, что вы прошли полный курс антибиотиков в соответствии с предписаниями врача, даже если вы почувствуете себя лучше до их окончания. В противном случае вы не сможете убить все бактерии, что сделает их устойчивыми к антибиотикам.
Если у вас большой фурункул или другое поражение, вам может потребоваться его дренирование.Не поддавайтесь желанию выпить или осушить его самостоятельно. Это может вызвать распространение инфекции.
Легкие стафилококковые инфекции часто проходят самостоятельно без какого-либо лечения.
Однако некоторые стафилококковые инфекции могут быстро стать серьезными и вызвать определенные осложнения, например:
- Целлюлит. Инфекция возникает в более глубоких слоях кожи.
- Тромбоз кавернозного синуса.
 Это редкое, но серьезное осложнение носовых или лицевых инфекций связано с образованием сгустка крови в основании вашего мозга.
Это редкое, но серьезное осложнение носовых или лицевых инфекций связано с образованием сгустка крови в основании вашего мозга. - Сепсис. Это состояние, потенциально опасное для жизни, является крайней реакцией вашего организма на инфекцию.
Бактерии стафилококка обычно присутствуют в полости носа и на коже. Обычно эти бактерии безвредны. Но они могут вызвать инфекцию, если попадут в ваше тело через разрыв кожи.
Если вы заметили в носу покраснение или раздражение, не спускайте с него глаз. Если он становится болезненным, образует шишку или поражение, заполненное гноем или жидкостью, обратитесь за медицинской помощью, чтобы избежать более серьезной инфекции.
Стафилококковая инфекция в носу: симптомы, лечение и диагностика
Стафилококковая или стафилококковая инфекция – это инфекция, вызываемая бактериями Staphylococcus aureus.
Многие люди переносят Staphylococcus aureus ( S.aureus ) на коже или в носу.
Здесь мы рассмотрим различные причины и симптомы инфекции носа стафилококка. Мы также обрисовываем доступные варианты лечения инфекции стафилококка носа, а также несколько советов по профилактике.
Поделиться на Pinterest Чрезмерное сморкание или потирание носа – возможная причина инфекции носа стафилококка.Бактерии S. aureus вызывают инфекцию стафилококка.
Около 20–80% людей носят S. aureus в носовых проходах. В большинстве случаев бактерии не причиняют никакого вреда. Однако при повреждении кожи носа бактерии могут попасть в рану и вызвать инфекцию.
Повреждение поверхности кожи может вызвать легкую или умеренную инфекцию стафилококка.Повреждение более глубоких слоев кожи может вызвать серьезную или даже опасную для жизни инфекцию стафилококка.
Бактерии стафилококка заразны и могут передаваться другим людям посредством:
- контакта кожи с кожей
- совместного использования личных вещей, таких как зубные щетки, бритвы или мочалки
- кашля или чихания, хотя эти типы передачи реже общий
Инфекция стафилококка в носу может возникнуть в результате царапины, язвы или других повреждений кожи носа.
Некоторые потенциальные причины инфекции стафилококка носа включают:
- ковыряние в носу
- чрезмерное сморкание или трение носа
- выщипывание или выщипывание носовых волосков
У человека с инфекцией стафилококка носа могут развиться следующие симптомы:
- покраснение и припухлость носа
- корка вокруг ноздрей
- фурункул внутри одной или обеих ноздрей
- отек лица
- боль
- лихорадка
В некоторых случаях инфекция стафилококка может исчезнуть сама по себе.В других случаях человеку потребуется лечение, чтобы избавиться от инфекции и предотвратить дальнейшие осложнения.
Некоторым людям удается вылечить небольшие носовые инфекции в домашних условиях. Чтобы успокоить язвы и корки, можно приложить чистую, теплую, влажную ткань к пораженным участкам. После этого важно вымыть ткань, чтобы избежать распространения бактерий.
У некоторых людей внутри ноздрей могут появиться гнойные нарывы. Врач должен осушить фурункул, чтобы вылечить инфекцию и ускорить заживление ран.Эта процедура обычно включает использование местного анестетика.
Врач должен осушить фурункул, чтобы вылечить инфекцию и ускорить заживление ран.Эта процедура обычно включает использование местного анестетика.
Если инфекция носового стафилококка не проходит сама по себе, человеку может потребоваться пероральный прием антибиотиков или применение местных антимикробных препаратов.
Без лечения стафилококковые инфекции могут рецидивировать. Это потому, что S.aureus остается внутри носовых ходов.
Лечение антибиотиками по рецепту может уменьшить количество бактерий стафилококка, тем самым помогая предотвратить повторение инфекции стафилококка.
Исследователи изучали лучшее лечение для предотвращения рецидивирующих инфекций стафилококка. Согласно обзору 2015 года, местные противомикробные препараты могут быть более эффективными, чем пероральные антибиотики. Это связано с тем, что S. aureus может иметь более низкую устойчивость к местному лечению.
Соблюдение правил личной гигиены также может помочь снизить риск повторных инфекций.
Попадание стафилококковой инфекции в кровоток может вызвать серьезные осложнения.Ниже мы перечисляем некоторые возможные осложнения.
Целлюлит лица
Целлюлит лица – это бактериальная инфекция, поражающая более глубокие слои кожи. Без лечения состояние может быть опасным для жизни.
Симптомы лицевого целлюлита включают:
Тромбоз кавернозного синуса
Тромбоз кавернозного синуса (CST) – это сгусток крови, который образуется в кавернозных синусах. Это полое пространство между мозгом и глазницами.
CST может развиться, когда инфекция лица или черепа распространяется на кавернозные синусы.Хотя это редко, состояние может быть опасным для жизни.
Симптомы CST включают:
Эндокардит
Инфекция иногда может распространяться на внутреннюю оболочку камер сердца и клапанов. Медицинский термин для этого – эндокардит.
Симптомы эндокардита включают:
Пневмония
Пневмония – это медицинский термин, обозначающий воспаление одного или обоих легких. Обычно это происходит в результате инфекции.
Обычно это происходит в результате инфекции.
При пневмонии крошечные воздушные мешочки или альвеолы в легких заполняются жидкостью или гноем.Это затрудняет дыхание человека.
Некоторые общие симптомы пневмонии включают:
- учащенное или поверхностное дыхание
- одышка даже в состоянии покоя
- боль в груди, усиливающаяся при дыхании или кашле
- учащенное сердцебиение
- лихорадка
- озноб
- общее плохое самочувствие
- потеря аппетита
Сепсис
Сепсис – это потенциально опасное для жизни состояние, при котором иммунная система организма чрезмерно реагирует на инфекцию.Эта чрезмерная реакция приводит к токсическому накоплению химических веществ в крови.
Симптомы сепсиса включают:
- учащенное дыхание
- учащенное сердцебиение
- лихорадка
- озноб
- чувство замешательства или дезориентации
синдром токсического шока
синдром токсического шока (СТШ) – редкое состояние, при котором Бактерии стафилококка выделяют опасные уровни токсинов в кровоток. СТШ может быть опасным для жизни.
СТШ может быть опасным для жизни.
Симптомы СТШ возникают внезапно и быстро ухудшаются.К ним относятся:
- лихорадка
- симптомы гриппа, такие как головная боль, ломота в теле и боль в горле
- тошнота и рвота
- диарея
- широко распространенная кожная сыпь, похожая на солнечный ожог
- яркая красный цвет губ, языка и белков глаз
- затрудненное дыхание
- обморок
- спутанность сознания
Есть меры, которые человек может предпринять, чтобы снизить риск развития или распространения стафилококковой инфекции носа или кожи.К ним относятся:
- регулярное мытье рук с мылом и чистой водой
- ежедневное принятие душа или ванны для поддержания чистоты кожи
- покрытие любых порезов или ран стерильными повязками или повязками
- избегание совместного использования личных вещей, таких как зубные щетки, бритвы и т. Д. мочалки
- , закрывающие рот и нос при кашле или чихании
- удаление салфеток после сморкания
- избегание ковыряния в носу
- использование только стерильного оборудования для выщипывания или выщипывания носовых волос или отказ от этих методов вообще
Некоторые стафилококки инфекции могут исчезнуть сами по себе, в то время как другим может потребоваться лечение.
Люди должны обратиться к врачу, если инфекция стафилококка:
- тяжелая
- длится дольше недели или продолжает возвращаться
- ухудшается или распространяется на другие части лица
- вызывает кожную сыпь или покраснение
- вызывает жар или озноб
- вызывает затруднение дыхания или изменение частоты сердечных сокращений
Любой человек с ослабленной иммунной системой должен обратиться к врачу при первых признаках инфекции стафилококка. Сюда входят люди, которые:
Бактерии стафилококка обычно живут внутри носа и обычно безвредны.Однако при повреждении кожи носа бактерии могут попасть в рану и вызвать инфекцию.
У человека с инфекцией носового стафилококка могут появиться покраснение, язвы или корки вокруг ноздрей. Для лечения инфекции человеку могут потребоваться антибиотики или местные противомикробные препараты.
Людям следует обращаться за лечением, если их инфекция носит тяжелый или постоянный характер или сопровождается другими симптомами. Людям с ослабленной иммунной системой следует как можно скорее обратиться за лечением, чтобы снизить риск осложнений.
Людям с ослабленной иммунной системой следует как можно скорее обратиться за лечением, чтобы снизить риск осложнений.
Стафилококковая инфекция в носу: симптомы, лечение и диагностика
Стафилококковая или стафилококковая инфекция – это инфекция, вызываемая бактериями Staphylococcus aureus.
Многие люди переносят Staphylococcus aureus ( S.aureus ) на коже или в носу.
Здесь мы рассмотрим различные причины и симптомы инфекции носа стафилококка. Мы также обрисовываем доступные варианты лечения инфекции стафилококка носа, а также несколько советов по профилактике.
Поделиться на Pinterest Чрезмерное сморкание или потирание носа – возможная причина инфекции носа стафилококка.Бактерии S. aureus вызывают инфекцию стафилококка.
Около 20–80% людей носят S. aureus в носовых проходах. В большинстве случаев бактерии не причиняют никакого вреда. Однако при повреждении кожи носа бактерии могут попасть в рану и вызвать инфекцию.
Повреждение поверхности кожи может вызвать легкую или умеренную инфекцию стафилококка.Повреждение более глубоких слоев кожи может вызвать серьезную или даже опасную для жизни инфекцию стафилококка.
Бактерии стафилококка заразны и могут передаваться другим людям посредством:
- контакта кожи с кожей
- совместного использования личных вещей, таких как зубные щетки, бритвы или мочалки
- кашля или чихания, хотя эти типы передачи реже общий
Инфекция стафилококка в носу может возникнуть в результате царапины, язвы или других повреждений кожи носа.
Некоторые потенциальные причины инфекции стафилококка носа включают:
- ковыряние в носу
- чрезмерное сморкание или трение носа
- выщипывание или выщипывание носовых волосков
У человека с инфекцией стафилококка носа могут развиться следующие симптомы:
- покраснение и припухлость носа
- корка вокруг ноздрей
- фурункул внутри одной или обеих ноздрей
- отек лица
- боль
- лихорадка
В некоторых случаях инфекция стафилококка может исчезнуть сама по себе. В других случаях человеку потребуется лечение, чтобы избавиться от инфекции и предотвратить дальнейшие осложнения.
В других случаях человеку потребуется лечение, чтобы избавиться от инфекции и предотвратить дальнейшие осложнения.
Некоторым людям удается вылечить небольшие носовые инфекции в домашних условиях. Чтобы успокоить язвы и корки, можно приложить чистую, теплую, влажную ткань к пораженным участкам. После этого важно вымыть ткань, чтобы избежать распространения бактерий.
У некоторых людей внутри ноздрей могут появиться гнойные нарывы. Врач должен осушить фурункул, чтобы вылечить инфекцию и ускорить заживление ран.Эта процедура обычно включает использование местного анестетика.
Если инфекция носового стафилококка не проходит сама по себе, человеку может потребоваться пероральный прием антибиотиков или применение местных антимикробных препаратов.
Без лечения стафилококковые инфекции могут рецидивировать. Это потому, что S.aureus остается внутри носовых ходов.
Лечение антибиотиками по рецепту может уменьшить количество бактерий стафилококка, тем самым помогая предотвратить повторение инфекции стафилококка.
Исследователи изучали лучшее лечение для предотвращения рецидивирующих инфекций стафилококка. Согласно обзору 2015 года, местные противомикробные препараты могут быть более эффективными, чем пероральные антибиотики. Это связано с тем, что S. aureus может иметь более низкую устойчивость к местному лечению.
Соблюдение правил личной гигиены также может помочь снизить риск повторных инфекций.
Попадание стафилококковой инфекции в кровоток может вызвать серьезные осложнения.Ниже мы перечисляем некоторые возможные осложнения.
Целлюлит лица
Целлюлит лица – это бактериальная инфекция, поражающая более глубокие слои кожи. Без лечения состояние может быть опасным для жизни.
Симптомы лицевого целлюлита включают:
Тромбоз кавернозного синуса
Тромбоз кавернозного синуса (CST) – это сгусток крови, который образуется в кавернозных синусах. Это полое пространство между мозгом и глазницами.
CST может развиться, когда инфекция лица или черепа распространяется на кавернозные синусы. Хотя это редко, состояние может быть опасным для жизни.
Хотя это редко, состояние может быть опасным для жизни.
Симптомы CST включают:
Эндокардит
Инфекция иногда может распространяться на внутреннюю оболочку камер сердца и клапанов. Медицинский термин для этого – эндокардит.
Симптомы эндокардита включают:
Пневмония
Пневмония – это медицинский термин, обозначающий воспаление одного или обоих легких. Обычно это происходит в результате инфекции.
При пневмонии крошечные воздушные мешочки или альвеолы в легких заполняются жидкостью или гноем.Это затрудняет дыхание человека.
Некоторые общие симптомы пневмонии включают:
- учащенное или поверхностное дыхание
- одышка даже в состоянии покоя
- боль в груди, усиливающаяся при дыхании или кашле
- учащенное сердцебиение
- лихорадка
- озноб
- общее плохое самочувствие
- потеря аппетита
Сепсис
Сепсис – это потенциально опасное для жизни состояние, при котором иммунная система организма чрезмерно реагирует на инфекцию. Эта чрезмерная реакция приводит к токсическому накоплению химических веществ в крови.
Эта чрезмерная реакция приводит к токсическому накоплению химических веществ в крови.
Симптомы сепсиса включают:
- учащенное дыхание
- учащенное сердцебиение
- лихорадка
- озноб
- чувство замешательства или дезориентации
синдром токсического шока
синдром токсического шока (СТШ) – редкое состояние, при котором Бактерии стафилококка выделяют опасные уровни токсинов в кровоток. СТШ может быть опасным для жизни.
Симптомы СТШ возникают внезапно и быстро ухудшаются.К ним относятся:
- лихорадка
- симптомы гриппа, такие как головная боль, ломота в теле и боль в горле
- тошнота и рвота
- диарея
- широко распространенная кожная сыпь, похожая на солнечный ожог
- яркая красный цвет губ, языка и белков глаз
- затрудненное дыхание
- обморок
- спутанность сознания
Есть меры, которые человек может предпринять, чтобы снизить риск развития или распространения стафилококковой инфекции носа или кожи. К ним относятся:
К ним относятся:
- регулярное мытье рук с мылом и чистой водой
- ежедневное принятие душа или ванны для поддержания чистоты кожи
- покрытие любых порезов или ран стерильными повязками или повязками
- избегание совместного использования личных вещей, таких как зубные щетки, бритвы и т. Д. мочалки
- , закрывающие рот и нос при кашле или чихании
- удаление салфеток после сморкания
- избегание ковыряния в носу
- использование только стерильного оборудования для выщипывания или выщипывания носовых волос или отказ от этих методов вообще
Некоторые стафилококки инфекции могут исчезнуть сами по себе, в то время как другим может потребоваться лечение.
Люди должны обратиться к врачу, если инфекция стафилококка:
- тяжелая
- длится дольше недели или продолжает возвращаться
- ухудшается или распространяется на другие части лица
- вызывает кожную сыпь или покраснение
- вызывает жар или озноб
- вызывает затруднение дыхания или изменение частоты сердечных сокращений
Любой человек с ослабленной иммунной системой должен обратиться к врачу при первых признаках инфекции стафилококка. Сюда входят люди, которые:
Сюда входят люди, которые:
Бактерии стафилококка обычно живут внутри носа и обычно безвредны.Однако при повреждении кожи носа бактерии могут попасть в рану и вызвать инфекцию.
У человека с инфекцией носового стафилококка могут появиться покраснение, язвы или корки вокруг ноздрей. Для лечения инфекции человеку могут потребоваться антибиотики или местные противомикробные препараты.
Людям следует обращаться за лечением, если их инфекция носит тяжелый или постоянный характер или сопровождается другими симптомами. Людям с ослабленной иммунной системой следует как можно скорее обратиться за лечением, чтобы снизить риск осложнений.
Staph может скрываться глубоко в носу, результаты исследования | Центр новостей
Shutterstock.comНовое исследование показывает, что бактерии стафилококка могут скрываться глубоко внутри носа.
Ученые из Медицинской школы Стэнфордского университета обнаружили, что ранее не замеченные участки глубоко внутри носа могут быть резервуарами для золотистого стафилококка , основной бактериальной причины заболевания.
Результаты их исследования были опубликованы 11 декабря в журнале Cell Host & Microbe .
Исследователи из Стэнфорда далее обнаружили обратную связь между присутствием S. aureus на этих участках и присутствием другого вида бактерий, Corynebacterium pseudodiphtheriticum , что позволяет предположить, что эти два организма конкурируют друг с другом и что C. pseudodiphtheriticum – или какой-либо молекулярный продукт, который он выделяет, – может оказаться полезным в борьбе с инфекциями, вызванными S. aureus .
«Около трети всех людей настойчивы S.aureus , еще одна треть – случайные носители, а оставшаяся треть, похоже, вообще не несет S. aureus », – сказал Дэвид Релман, доктор медицины, профессор Томаса К. и Джоан М. Мериган и профессор медицины и медицины. микробиология и иммунология. Релман, который также является руководителем отдела инфекционных заболеваний в системе здравоохранения Пало-Альто по делам ветеранов, был старшим автором исследования. Ведущим автором был Милинг Ян, доктор философии, аспирант лаборатории Релмана на момент проведения экспериментов.
Ведущим автором был Милинг Ян, доктор философии, аспирант лаборатории Релмана на момент проведения экспериментов.
«Давно известно, что нос является основным резервуаром S. aureus », – сказал Релман. Жук также изобилует кожей, особенно в подмышечных впадинах и паху. Однако в подавляющем большинстве случаев это мало или не причиняет никакого вреда. (Если это приносит пользу, то никто еще не понял, что это такое, добавил Релман.)
Но если кожа повреждена, например, раной, медицинским разрезом или размещением катетера, S. aureus может попасть в кровоток и вызвать серьезные и даже опасные для жизни проблемы, такие как сепсис, пневмония или инфекция сердца. клапаны.Около половины всех штаммов S. aureus устойчивы к семейству антибиотиков, включая метициллин. В 2011 году только в Соединенных Штатах произошло более 80 000 тяжелых метициллин-устойчивых инфекций S. aureus , а также более 11 000 связанных смертей, а также гораздо большее количество менее тяжелых инфекций.
«Не все, у кого есть S. aureus , заболевают», – сказал Релман. «Когда они гуляют по улице и в остальном здоровы, пытается избавить их от своих S.aureus не нужны, а иногда и бесполезны. Но как только носитель попадает в больницу с основным заболеванием, с ослабленной иммунной системой или с высокой вероятностью прохождения процедур, проникающих через кожу, носительство S. aureus становится серьезной проблемой ».
Существуют строгие и несколько утомительные схемы уничтожения S. aureus , обитающего на коже людей или в их носу, но обычно это вопрос недель или месяцев, прежде чем бактерии снова заселят людей, чувствительных к этому заболеванию.Новое исследование предлагает возможную причину этого.
Ученые набрали 12 здоровых субъектов и доставили их в Стэнфордскую клинику ушей, носа и горла, которой руководит соавтор исследования Питер Хван, доктор медицины, профессор отоларингологии. Используя специальные инструменты, позволяющие направлять крошечные мазки в определенные места внутри носа, они взяли образцы из трех конкретных областей. Первым местом – и, безусловно, наиболее хорошо изученным, поскольку оно гораздо более доступным, – был передний нерв, относительно сухой участок ткани, похожий на кожу, расположенный около ноздри.Вторым был средний проход – более теплая, влажная, продуцирующая слизь складка, обнаруженная примерно на полпути вверх по носовой полости. И третьим было клиновидно-этмоидальное углубление, расположенное глубоко внутри полости около крыши носа и, как и средний проход, теплое, влажное и слизистое.
Первым местом – и, безусловно, наиболее хорошо изученным, поскольку оно гораздо более доступным, – был передний нерв, относительно сухой участок ткани, похожий на кожу, расположенный около ноздри.Вторым был средний проход – более теплая, влажная, продуцирующая слизь складка, обнаруженная примерно на полпути вверх по носовой полости. И третьим было клиновидно-этмоидальное углубление, расположенное глубоко внутри полости около крыши носа и, как и средний проход, теплое, влажное и слизистое.
Дэвид Релман
Исследователи обнаружили, что наличие или отсутствие S. aureus на одном носовом участке обычно коррелирует с его присутствием или отсутствием на двух других. Подразумевается: если передняя ноздря человека является переносчиком бактерий, вероятно, и верхние области слизистой оболочки тоже.Возможно, именно поэтому попытки изгнать S. aureus так часто оказывались недолговечными. Сосредоточение усилий в основном на бактериях в переднем отделе носа, как это делают современные процедуры деколонизации, оставляет нетронутыми более глубокие резервуары.
Релмана узнала еще три вещи. Во-первых, относительная численность S. aureus была обратно пропорциональна относительной численности другого вида бактерий, C. pseudodiphtheriticum . Когда один присутствовал на высоких уровнях, другой присутствовал на низких уровнях или отсутствовал.Один из соавторов исследования, доктор философии Сундж Памп, научный сотрудник лаборатории Релмана, поместил два вида бактерий на чашку с агаром для дальнейшего изучения этой взаимосвязи и обнаружил, что C. pseudodiphtheriticum сильно блокирует рост S. .aureus .
Исследователи подозревают, что что-то C. pseudodiphtheticum производит и секретирует – возможно, белок или, возможно, небольшую молекулу – что является причиной неспособности к развитию S. aureus ’.По словам Пэмпа, если такое вещество будет идентифицировано, это может дать ключ к разгадке разработки новых соединений для предотвращения или лечения инфекций, вызванных S. aureus .
Во-вторых, микробные сообщества у тех пациентов, которые являются носителями S. aureus , отличались другими способами от таковых у пациентов, которые этого не сделали. Это может означать, что S. aureus изменяет свою среду, делая его более или менее благоприятным для различных других микробов. Или это может означать, что разные микробные сообщества более или менее восприимчивы к колонизации S.aureus . В последнем случае можно будет предсказать, основываясь на их резидентных носовых микробах, какие пациенты с наибольшей вероятностью подвержены высокому риску заражения S. aureus – даже если они в настоящее время не переносят его и следить за ними и относиться к ним соответствующим образом. Те пациенты, которые относятся к группе более низкого риска, могут быть избавлены от таких процедур.
В-третьих, в среднем проходе и клиновидно-этмоидальном углублении – двух более глубоких и влажных областях слизистой оболочки носа – микробные сообщества были похожи друг на друга, но совершенно отличны от того, что населяет более доступный и лучше изученный внешний участок, передний Нарис. Это говорит о том, что обычные в настоящее время методы отбора проб из носовой полости для исследования микробов могут давать искаженные результаты.
Это говорит о том, что обычные в настоящее время методы отбора проб из носовой полости для исследования микробов могут давать искаженные результаты.
Другими соавторами исследования были аспирант Джулия Фукуяма; резидент-отоларинголог До-Ён, доктор медицины; и профессор статистики Сьюзан Холмс, доктор философии. Исследование финансировалось Пионерской премией Национального института здравоохранения (грант DP1OD000964), Благотворительным фондом Дорис Дьюк и Фондом Томаса К. и Джоан М. Мериган.
Информация о Департаменте микробиологии и иммунологии и Департаменте медицины Стэнфорда, которые также поддержали эту работу, доступна по адресу http: // microimmuno.stanford.edu и http://medicine.stanford.edu соответственно.
.





 Обязательно очищайте зоны под ногтями, между пальцами и запястья. Вытирайте руки одноразовыми полотенцами (например, бумажными). Если нет возможности воспользоваться мылом и водой, можно использовать антисептик для рук на основе спирта. Втирайте антисептик по всей поверхности рук, пальцев и запястий до полного высыхания.
Обязательно очищайте зоны под ногтями, между пальцами и запястья. Вытирайте руки одноразовыми полотенцами (например, бумажными). Если нет возможности воспользоваться мылом и водой, можно использовать антисептик для рук на основе спирта. Втирайте антисептик по всей поверхности рук, пальцев и запястий до полного высыхания. Это инфекция передней части носовой полости. Это может вызвать корки и кровотечение.
Это инфекция передней части носовой полости. Это может вызвать корки и кровотечение.
 Это редкое, но серьезное осложнение носовых или лицевых инфекций связано с образованием сгустка крови в основании вашего мозга.
Это редкое, но серьезное осложнение носовых или лицевых инфекций связано с образованием сгустка крови в основании вашего мозга. Это редкое, но серьезное осложнение носовых или лицевых инфекций связано с образованием сгустка крови в основании вашего мозга.
Это редкое, но серьезное осложнение носовых или лицевых инфекций связано с образованием сгустка крови в основании вашего мозга.